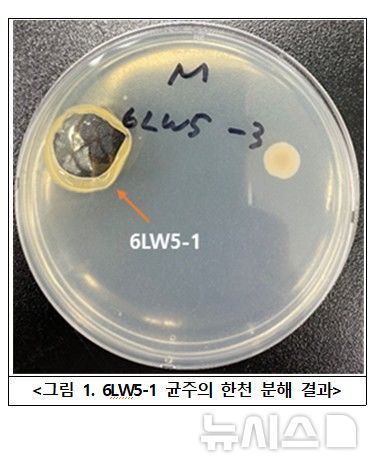

신종 미생물에서 발견한 효소로 기능성 올리고당 생산의 기반이 마련됐다.
뉴시스 보도에 따르면, 환경부 산하 국립낙동강생물자원관은 신종 미생물로부터 '한천(우뭇가사리과)'을 분해하는 효소를 확보하고, 이를 통해 기능성 올리고당 생산 가능성을 확인했다고 6일 밝혔다.
앞서 연구진은 2022년 6월 강릉 경포호에서 한천 분해 능력이 뛰어난 신종 미생물을 발견했다.
경포호는 민물과 바닷물이 만나는 독특한 생태 환경을 갖춘 곳이다. 이곳에서 발견된 신종 미생물은 한천 등 해조류의 주요 성분인 아가로오스를 분해하는 '베타-아가레이즈' 효소를 보유하고 있다.
연구진의 실험 결과, 베타 아가레이즈는 한천의 아가로오스를 분해해 기능성 올리고당인 '네오아가로비오스'와 '네오아가로테트라오스'를 효과적으로 생산하는 것으로 나타났다.
이들 물질은 장내 유익균 증식, 면역 기능 강화 등 건강 기능성이 보고된 바 있어 향후 식품과 화장품, 의약 소재로의 활용될 것으로 연구진은 기대했다.
국립낙동강생물자원관은 "이번 연구 결과를 바탕으로 2건의 특허를 지난 6월 말 출원했다"며 "향후 효소의 기능 향상을 위한 후속 연구를 통해 산업적 활용성과 상용화를 확대하겠다"고 밝혔다.
Copyright ⓒ 모두서치 무단 전재 및 재배포 금지
본 콘텐츠는 뉴스픽 파트너스에서 공유된 콘텐츠입니다.



